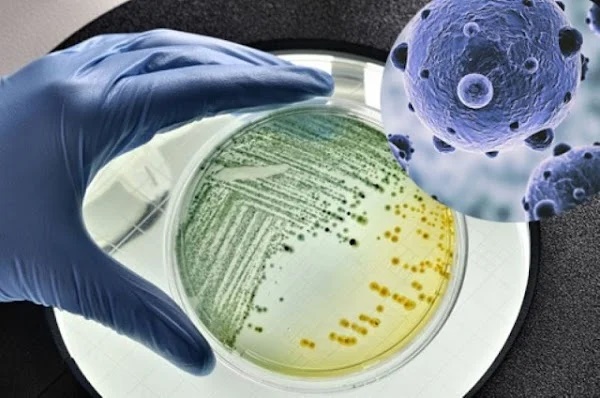

Mọi người hay dọn dẹp nhà cửa, vệ sinh vật dụng sạch sẽ nhưng chắc chắn vẫn bỏ sót một thứ với vô vàn vi khuẩn trú ngụ, có cả Mycobacterium, đó chính là vòi hoa sen.
Một nghiên cứu từ Đại học Colorado ở Boulder (Mỹ) đã cảnh báo, chính điều này đã tăng nguy cơ nhiễm trùng phổi, mắc bệnh lao với các thành viên trong gia đình khi sử dụng vòi hoa sen bẩn.
Cho nên, khi mọi người nhận thấy áp lực nước giảm, lượng nước phun không đều hoặc phun sang một bên thì có nghĩa là đầu vòi sen đã bị đóng cặn gây tắc tia nước, đồng nghĩa đã có lượng vi khuẩn sinh sôi. Và việc cấp bách cần làm là phải vệ sinh vòi hoa sen ngay theo hướng dẫn dưới đây để nước chảy thông thoáng tiện dùng, hơn hết là đảm bảo sức khỏe cho cả nhà nhé.
Dùng giấm
Giấm có nhiều trong gian bếp mỗi nhà nhưng mọi người đừng chỉ biết dùng nó phục vụ cho việc nấu nướng. Bởi lẽ giấm cũng giúp ích rất nhiều trong việc vệ sinh vòi hoa sen. Cách làm rất đơn giản, chỉ cần cho giấm vào khoảng ⅔ túi nhựa rồi khéo léo cho đầu vòi sen vào túi giấm buộc kín.

Để khoảng vài giờ hoặc để qua đêm đến sáng hôm sau chỉ cần tháo túi đựng giấm ra và xả nước với lực mạnh nhất thì sẽ tống khứ được hết cặn. Ai kỹ hơn thì có thể lấy bàn chải đánh răng cũ chà xát qa các lỗ nhỏ trên vòi hoa sen cho thật sạch sẽ.
Dùng baking soda
Đối với vòi hoa sen đã quá lâu ngày chưa được vệ sinh, xuất hiện những đốm đen thì cần phải có một nguyên liệu nữa kết hợp với giấm, đó chính là baking soda.

Chúng ta chỉ cần trộn đều giấm và baking soda thành hỗn hợp sền sệt, sau đó cho vào túi nhựa. Rồi cũng lại thực hiện thao tác cũ là đặt đầu vòi hoa sen vào túi hỗn hợp, buộc kín để khoảng 1 ngày. Hôm sau dùng bàn chải đánh răng hay tăm nhọn vệ sinh lại các lỗ và xả nước thì vòi hoa sen sẽ sạch sẽ hoàn toàn, có thể tắm gội thoải mái.
Theo Sài Gòn Thể Thao
